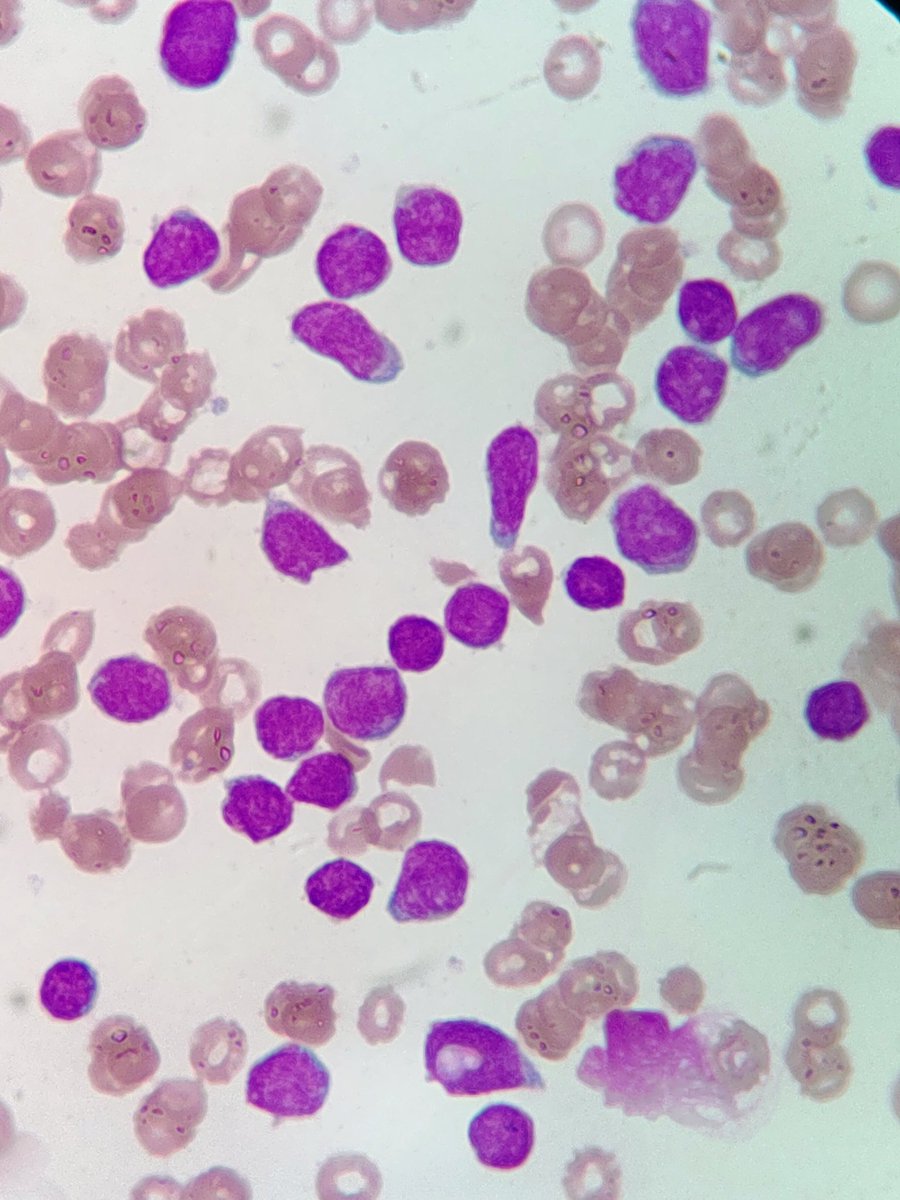
La interconsulta de la semana.

Dr. Acula
@eritrocitorojo
Hemato-Pediatra 🩺 & Trasplante de Médula Osea 🧬
Coffee is a cup of hope in a world full of chaos and mondays.
Philadelphia Eagles 🦅🏈
ID: 111918607
https://www.researchgate.net/profile/Gerardo-Lopez-Hernandez 06-02-2010 16:00:38
2,2K Tweet
212 Followers
1,1K Following







highlights of the 2025 ESPYS Awards Shane Gillis 🦅💚!




¡¡DINÁMICA!! Si los 49ers vencen a los Rams, rifaremos $5,000 MXN entre las personas que den like y repost a esta publicación. Deben de estar siguiendo a nuestros amigos de Águila Picks para participar. Suerte a todos!